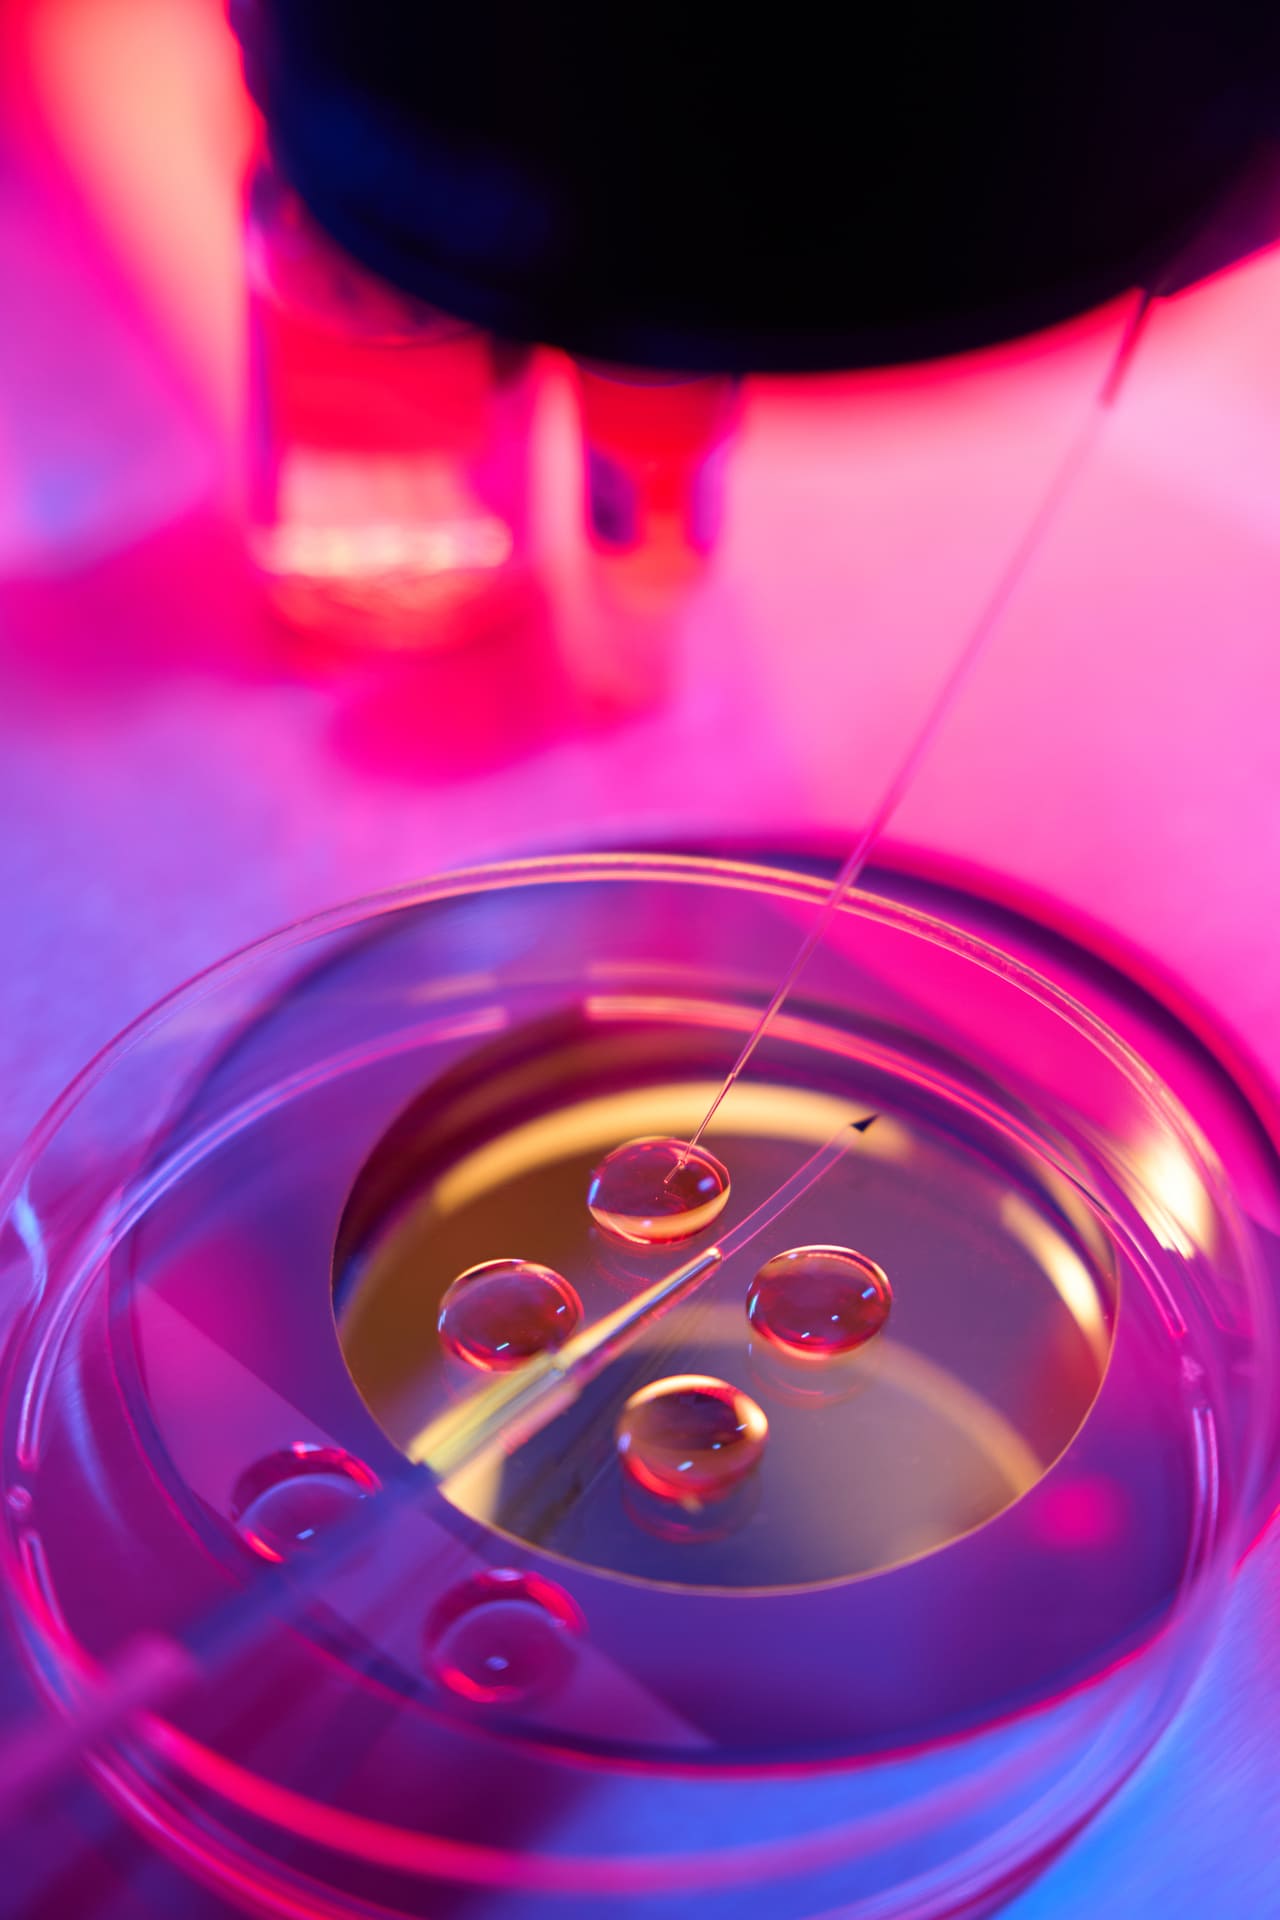
Close-up of ICSI procedure in lab, eggs under microscope for implantation after ALICE test detected chronic endometritis.

- About Us
- Fertility Treatments
- Fertility Investigations
- Advanced Reproductive Technology
- Underlying Conditions
- Contact
- Blog
En
- About Us
- Fertility Treatments
- Fertility Investigations
- Advanced Reproductive Technology
- Underlying Conditions
- Contact
- Blog
En